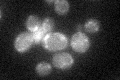
YBR238C
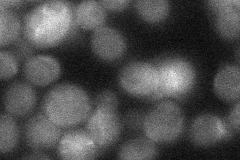
YBR238C
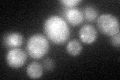
YBR238C

View description
Mitochondrial membrane protein with similarity to Rmd9p; not required for respiratory growth but causes a synthetic respiratory defect in combination with rmd9 mutations; transcriptionally up-regulated by TOR; deletion increases life span
Localization:
Intensity:
Fold change:
Significance:
-
C’ GFP library in SD
mitochondria25.58 -
N' NOP1pr-GFP in SD

cytosol67.1903 -
N' TEF2pr-mCherry in SD

cytosol35.4751 -
N' NATIVEpr-GFP in SD
cytosol24.1267 -
N' TEF2pr-VC and Cyto-VN in SD

cytosol33.315 -
C’ GFP library in SD+DTT
mitochondria22.120.86No -
C’ GFP library in SD+H2O2

mitochondria23.580.92No -
C’ GFP library in Starvation Media

mitochondria17.830.69Yes -
C’ GFP library on the background of Pup2-DaMP

mitochondria -
C’ GFP library on the background of CCT mutant

mitochondria29.61691.15778No
